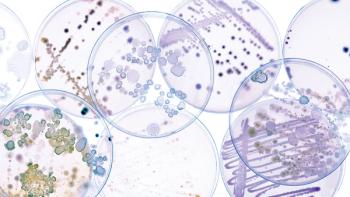

Engineered biosynthetic pathways provide new avenues for accessing complex molecules.

Cynthia A. Challener, PhD, is a contributing editor to BioPharm International.

Engineered biosynthetic pathways provide new avenues for accessing complex molecules.

Solutions are emerging to manage advanced modalities and evolving regulatory requirements for viral clearance.

Increasing efficiency and quality through effective application of advanced technologies is becoming predominant.

Advanced modeling provides greater understanding for more-informed decision making across all phases of drug development.

The increasing diversity and complexity of injectable drug products is driving innovation.

Incorporating sustainable practices into process designs as early as possible ensures optimal performance.

Hurdles exist across all aspects and phases of drug development and manufacturing.

Process consistency and robustness, analytical excellence, and regulatory compliance are essential in the scale-up of biosimilars.

Exosomes, polymeric nanoparticles, and DNA nanostructures offer many potential advantages.

The benefits include reduced contamination risks, simplified validation processes, and streamlined operations.

Cell-line engineering and media formulation improvements are leading to greater performance.

Developers save money and time while accessing expertise.

Synthesis of DNA via cell-free methods has many benefits versus fermentation.
Many factors must be considered to overcome the challenges associated with viral clearance.

The best strategy is to use a combination of complementary methods.

Weighing development costs/resources and performance benefits is essential.

Collaboration between technology providers and biopharma manufacturers are enabling both evolutionary and novel developments.

Platform processes and effective risk assessments help overcome time and cost challenges.

Gamma irradiation is being supplemented with alternative technologies.

Using a multi-pronged strategy to find optimum, tailored formulations is best.

Sterile filtration and use of sterile single-use materials provide the best solutions depending on vector size.

Increases in efficiencies, flexibility, scalability, and sustainability are impacting adoption.

Proprietary cell lines offer opportunities for achieving high AAV titers.

Buffers, stabilizers, and cryoprotectants play major roles in cell therapy formulations.

Developing freeze-drying processes requires patience and deep product and process understanding.

Product and process understanding are essential to effective resin selection.

A look at how linker technology for antibody drug conjugates has evolved.

Preparing for variability and flexible processing are necessary for success.

There is no such thing as a perfect linker.

Using a systematic approach and achieving run-to-run consistency are essential.

Published: March 8th 2025 | Updated:

Published: February 1st 2024 | Updated:

Published: December 1st 2022 | Updated:

Published: April 2nd 2021 | Updated:

Published: January 1st 2024 | Updated:

Published: August 1st 2022 | Updated: